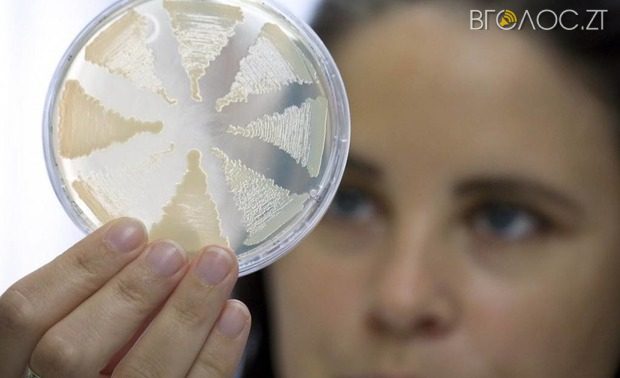

Епідситуація за І квартал 2019 року.
Позначка: ботулізм
З початку року в області зареєстрували 2 спалахи інфекцій кишкової групи
З початку року у Житомирській області зареєстрували два спалахи інфекцій кишкової групи. Постраждали 32 дитини віком до 17 років. Про це повідомили у головному управлінні Держпродспоживслужби...
У Бердичеві зафіксували перший випадок ботулізму після вживання консервованих грибів
Постраждала 19-річна дівчина.